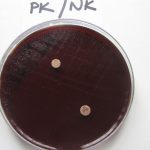

Near East University Experimental Health Sciences Research Center (DESAM) and the Faculty of Pharmacy have conducted a significant research on the plants indigenous to Cyprus. The scientists have reached results that thymus capitatus (thyme), raw prunus amygdalus dulcis (almond) and corchorus olitorius (mulukhiyah) can be used for the treatment of the gastrointestinal diseases and cancer as well as in pharmacy.
Near East University Directorate of Press and Public Relations Office released that three scientific projects regarding the pharmaceutical assessments of the plants indigenous to Cyprus had been conducted with the support of Near East University Scientific Research Projects Coordination Unit. Studies present significant findings that essential oils extracted from aforementioned plants are effective in the treatment of gastrointestinal diseases and cancer.
The studies present findings that the essential oil extracted from thyme (thymus capitatus) kills the bacteria that cause gastrointestinal diseases, the essential oil extracted from raw almond (prunus amygdalus dulcis) is effective in preventing colon cancer and metastasis. It was also observed that the plant of mulukhiyah (corchorus olitorius L.) was found to be effective on the colon cancer cells.
Thyme has a lethal effect on Helicobacter Pylori Bacterium which causes gastrointestinal diseases…
The studies that conduced to investigate the pharmaceutical use of the essential oil extracted from thyme (Thymus capitatus); a plant species that is common in Cyprus, present findings obtained through in vitro analysis realized in DESAM (Experimental Health Sciences Research Center) laboratories. The results of the in vitro analysis clearly show that thyme oil has a lethal effect on Helicobacter pylori which can cause Gastritis, Duodenal ulcers, stomach cancer and gastric lymphoma.
Raw Almond and Mulukhiyah are effective to Prevent the Cancer Cells…
The results of the analysis and evaluations that carried out within the scope of the project titled “Pharmaceutical Evaluation of the Raw Almonds native to Northern Cyprus” were published in the international Pharmaceutical Biology journal. The results of in vitro experiments on the essential oil extracted from the non-roasted almonds native to Yedidalga village show that raw almond oil has potential to be effective in preventing colon cancer and metastasis.
Another study conducted in collaboration with the Near East University Experimental Health Sciences Research Center (DESAM) and Manisa Celal Bayar University presents results that mulukhiyah; a plant species native to Cyprus, has potential to be effective in colon cancer cells. Grounding on the data obtained through analysis, it was stated that the plant extract of Corchorus olitorius L. (mulukhiyah), a plant species commonly grown and consumed in Cyprus, had an anti-cancer effect in primary and metastatic colon cancer which can spread to other organs. The results of the study show that mulukhiyah has anti-cancer effects and the plant extract can be used as a potential drug in the treatment of colon cancer in the coming years.
Significant data regarding the conservation and economical use of plants indigenous to Cyprus have been obtained
Studies conducted on endemic plants were discussed in the scientific community, presented in congress and symposia and published in international journals. Studies conducted on plant species native to Cyprus will be reported and submitted to the Ministry of Health and the Ministry of Agriculture to be used as reference in the future studies. The studies also underline that the biodiversity, which has a significant potential in our country, is gradually decreasing. The studies draw attention not only to the importance of conserving and conveying the biodiversity to next generations but also to the necessity of maintaining and assessing the Cypriot flora in terms of using plant species in both agricultural and pharmaceutical industry.